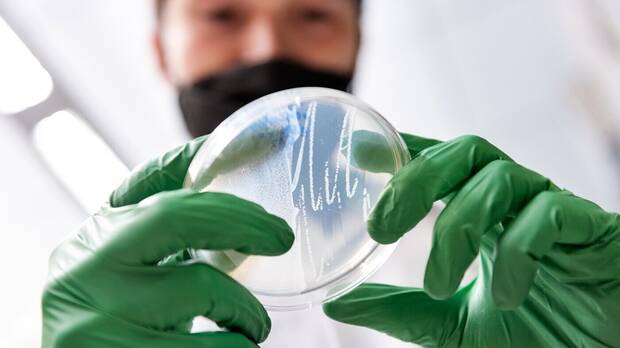
Cientfico ADN

Sam Altman, uno de los responsables de ChatGPT y OpenAI, ha invertido más de 180 millones de dólares en una compańía que busca retrasar el envejecimiento en los seres humanos. Sí, en una empresa de biotecnología que aboga por la búsqueda de la inmortalidad. Al igual que Jeff Bezos y su Alto Labs, Altman, que tiene en Microsoft a uno de los más poderosos aliados comerciales imaginables, ha depositado su confianza en Retro Biosciences.
Una apuesta persona de Sam Altman: el responsable de la inteligencia artificial más famosa busca la inmortalidad
Altman, como explican en MIT Technology Review, había invertido en el pasado más de 375 millones de dólares en Helion Energy, una startup que está intentando construir un reactor de fusión nuclear tras los últimos avances conseguidos en este área, y ahora ha depositado casi la mitad de ese dinero en una compańía bautizada como Retro Biosciences que busca retrasar la muerte y alargar la esperanza de vida de los seres humanos.
El responsable de Open AI, inteligencia artificial considerada demasiado woke por Elon Musk, ha depositado su confianza en esta compańía, y ya en el ańo 2021 dejó una considerable suma de dinero en sus arcas. żEl objetivo de Retro Biosciences? Expandir 10 ańos la esperanza de vida humana. Al parecer, la compańía no hizo pública su participación en las rondas de financiación hasta ahora para evitar que el nombre de Altman, muy conocido y relevante, se convirtiera en una distracción o un reclamo publicitario vacío.

En Retro Biosciences participan nombres como Joe Betts-LaCroix, Sheng Ding y Matt Buckley, biofísicos con objetivos claros como el de prolongar en unos 10 ańos la esperanza de vida de los seres humanos, así como en trabajan en prevenir múltiples enfermedades degenerativas.
Desde hace unos ańos, están invirtiendo, explican en su web oficial, en tecnologías como la multiómica unicelular y la biología computacional, todo ello basada en aprendizaje automático y en el poder de la inteligencia artificial. Sus responsables, remarcan desde sitios web como Gizmodo, apuntan a la reprogramación celular y terapias inspiradas en la autofagia y las intervenciones de plasma. Al menos, sobre el papel.
Los ensayos clínicos no ha comenzado todavía y queda mucho trabajo, pero se mantienen esperanzados con los avances en este campo de la biotecnología. Sam Altman, considerado un personaje excéntrico por sus extrańas aficiones, se ha considerado como un survivalista o prepper, personas que creen que el fin de la civilización está próximo, acumulando diferentes enseres e invirtiendo su dinero en empresas que intentan evitar que esto ocurra. Altman tienen un búnker en el que atesora armas, lingotes de oro, pastillas de yodo y potasio, medicinas de todo tipo, enormes cantidades de agua, baterías y máscaras de gas. Además, compró una porción de terreno para cultivar, algo que Bill Gates también ha hecho.
















